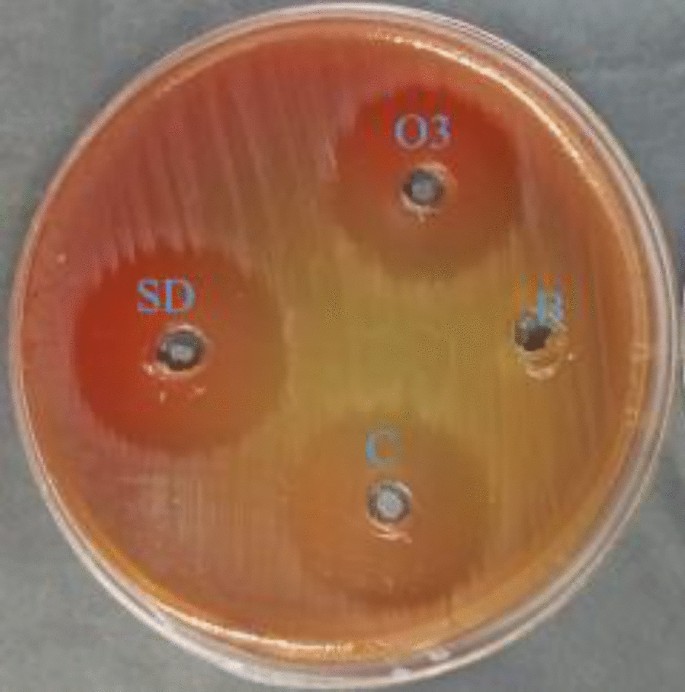
Fig. 2

Abstract
Pumpkin is a widely recognized plant in the Cucurbitaceae family because of its significance as a pharmaceutical food. Ozonized oils are becoming more popular among researchers and being employed in medical facilities due the continuous search for powerful biomedical medicines that can combat illnesses with controllable negative repercussions. Pumpkin seed oil was ozonized at an average rate of 0 to 8 L/minute. The chemical composition of the oil before and after treatment was characterized using Gas Chromatography-Mass Spectrometry (GC–MS) analysis. Anti- Helicobacter pylori (H. pylori) of both unrefined and ozonized pumpkin oils were detected using agar well diffusion technique. The anti-biofilm was tested at 25, 50 and 75% of MBC. Time killing assay was done to compare the antimicrobial impacts both refined and ozonized oils the various of the antibacterial impact at various time points. Anticancer role versus human prostate cancer cell line (PC-3) cells for oil forms was done using [3-(4,5-dimethylthiazol-2-yl)-2,5-diphenyltetrazolium bromide] MTT protocol. The change of cell cycles was compared in cancer cells and after treatment by examined oil forms. In vitro alpha glucosidase, alpha amylase and lipase enzymes inhibition was done in both oil samples relative to norms. Both oil forms contained 25 bioactive molecules where ozone exposure altered the molecular diversity with increased the number of classes of molecules in ozonized oil. Additionally, exposure to ozone significantly increased the levels of and n-propyl 9,12-octadecadienoate and 9-Hexadecenoic acid, 9-hexadecenyl ester, (Z, Z)- could be seen with high level in ozonized oil. A slight rise in anti-H. pylori could be seen in ozonized oil which showed bactericidal impact which had been confirmed by time killing assay. The anti-biofilm tested activity reached its maximal level upon using 75% of MBC of ozonized pumpkin seed oil. The ozonized oil had a promising anticancer role towards PC-3 cells through induction of early apoptosis. Exposure of pumpkin oil to the ozone led to improvement in in vitro antidiabetic and anti-obesity roles. These findings support the conclusion that being exposed to pumpkin oil to ozone improves the oil’s in vitro impact to pathogenic microbes and diseases that are not transmissible to be applied in preclinical applications in future studies.
Similar content being viewed by others
Introduction
Despite significant advancements in contemporary medicine, effective therapies for many diseases are still lacking. Due to the potential effectiveness, safety, and affordability of natural molecules, the need for natural therapies is increasing in developing nations1,2. In addition to providing the foundation for the emergence of innovative therapeutic approaches, basic research has advanced the knowledge of how to hinder these diseases3.
Pumpkin (Cucurbita pepo L.) is an annual climber valued for its seeds, which mature between August and October4. Oil from pumpkin seeds is a remarkably abundant source of several bioactive chemicals with useful qualities that can be utilized as culinary oil or possibly as a dietary supplement. The medicinal benefits of pumpkin seed oil, sometimes referred to as extremely dichromatic turbulent oil, have been the subject of numerous investigations in the past few decades5, it serves as a rich source of bioactive molecules—making them particularly relevant for investigating therapeutic properties such as anti-H. pylori, anticancer, and antidiabetic effects4. To date, investigators have concentrated especially on the fatty acid, tocopherol, and sterol levels and structure of pumpkin seed oil due to its beneficial implications for health6,7. Furthermore, because of its various health benefits, including its anti- diabetic properties8, antimicrobial9, antioxidant, and anti-inflammatory10 properties, pumpkin has received interest as an extraordinary preventive towards a variety of ailments, including high blood pressure and neoplastic diseases11,12. The assessment of pumpkin seed oil’s antioxidant capacity and biochemical characteristics would help increase its value, particularly in the culinary, skincare products, aiding in menopause symptom relief, enhance spermatogenesis and pharmacological sectors13.
It has been shown that ozone can be added to oils to further improve their antimicrobial qualities. As one of the most effective antimicrobials, ozone (O3) has been empirically employed as a clinical treatment agent14,15,16. The processes underlying this action are predicated on ozone’s stronger oxidizing capabilities, which lead to a rise in penetration and ozone’s admission to bacterial cells17. Additionally, ozone can activate the immune system’s inherent capacity to fight against microbes. Indeed, bacterial lipoproteins generate LOP (items of lipid degradation) in the existence of ozone, which can cause phagocytes to create more H2O2, improving bactericidal, bacteriostatic action, antioxidant impact and other biomedical applications18,19. This study contributes to existing knowledge, particularly in comparison with previous studies on ozonized oils and their biomedical effects4,6,7,9,15,16,18,19. The present work designed to test the chemical composition of unrefined pumpkin oil and after exposure to ozone. This study aimed to compare the antibacterial activity of ozonated and non-ozonated pumpkin seed oil against H. pylori, as well as evaluate their anticancer, antidiabetic, and anti-obesity potential.
Materials and methods
Chemicals
The used chemicals and reagents along the study were obtained from (Sigma, Egypt) company. pumpkin seed oil was purchased Ayurveda Company in Egypt.
Exposing the oil to ozone
An electric border shockwave plasma generator at IMSIU was used to create ozone gas. At the plasma reactor’s output, a 1.9 L drechsel cylinder holding 1.0 L of pumpkin seed oil was immersed in a chilling bath set at −7 °C. For six hours, the ozone bubbling in the pumpkin seed oil at an average rate of 0 to 8 L/minute, forming a semisolid state. Following ozonation, the pumpkin seed was taken out of the Drechsel vessel, transported to a glass container that was vacant determined, and stored at 8 °C20.
GC–MS examination
To examine the chemical composition pumpkin seed oil and its ozonized form using Gas chromatography. A flame-ionization detection device (FID), an auto-sampler (5710- Shimadzu, Japan), and a Rt-570 column (100.0 m × 0.26 mm × 0.21 µm; Shimadzu, Japan) were used for the GC tests. Details obtained from the FID were obtained using a chromatography apparatus (X-caliber data capture and software, Shimadzu, Japan). The transporter gas, helium, was administered with rip delivery (100:1). The pre-run timeout lasts for ten minutes. It takes 0.6 min to reach equilibrium. There were two ramps completed; ramp 1 had a rate of 6 °C/min and an ultimate temperature of 200 °C, while ramp 2 had a rate of 6 °C/min. Its ultimate temperature was 285 °C, with an initial temperature of 48 °C. Systemized heat mode was used for the tests, starting at 100 to 285 °C and proceeding to isothermal for 14.0 min. The 1.6 ml/min was a carrier flow rate. A comparison of the compounds’ mass spectra with information found in NIST 14 and 14 s (National Institute of Standards and Technologies, Mass Spectra Libraries) allowed for their identification. The internal standards were used to perform and adjust the calibration curves21.
Anti-H. pylori test
The unrefined and ozonized pumpkin seed oils were tested against H. pylori (ATCC26695) via the agar-well diffusing test using Mueller–Hinton (MH) media, according to standard of McFarland’s turbidity. The used The H. pylori inoculum was applied to the MH-containing agar’s surface using a sterilized cotton swab. After that, 100 μL of examined oils at a concentration of 100 mg/mL was added to the prepared the agar wells for test samples. A standard control of 0.05 μg/mL clarithromycin and a negative control of 10% dimethyl sulfoxide (DMSO) were added to different wells. The plate was kept for 32 min in a refrigerator at 5 °C to enable the specimens to spread out before H. pylori growth started. A GasPak™ anaerobic system“Oxoid”was used for incubating the plates holding the inoculums for 72 h, under a microaerobic condition at 36 °C. The resulting regions of inhibition were subsequently determined in millimeters22,23.
Determination of minimal inhibitory concentration (MIC) & minimum bactericidal concentration (MBC)
The MICs of the evaluated oils against H. pylori were ascertained using Mueller–Hinton broth as the micro-dilution broth. The evaluated oils were produced in a range of serial dilutions from 0.98 to 1000 μg/mL. 200 μL of the examined oils were added to each well of a 96-well microtiter plate. Sterile NaCl (0.86%) was utilized in preparing a fresh H. pylori inoculum in order to get the necessary McFarland visibility of 1.0. An ultimate concentration of 5.0 × 104 colony-forming units/mL was obtained by inoculating each well with 2 μL of the tested pathogen.
For 72 h, the plates had been incubated at 36 °C. The degree to which the tested pathogens’ overall growth was hindered was then determined by visually evaluating the MIC. Microplates with an H. pylori inoculum and no tested oils were used as positive controls, whereas microplates with the evaluated oils and no H. pylori were used as negative controls24. The micro-dilution plates used for the MIC test yielded the MBC. Mueller–Hinton agar plates were filled with 10 μL aliquots of each well that showed no signs of growth, and they underwent incubation for 72 h at 38 °C. The MBC is the lowest level of the oils under investigation that completely stopped H. pylori growth on the plates. The MBC/MIC ratio was used to describe the bacteriostatic or bactericidal properties of the tested oils. The samples are referred to as a substance that kills bacteria if its MBC/MIC ratio is no greater than fourfold the MIC value25.
Anti-biofilm assay
The effect of the tested oils on biofilm formation were evaluated in 96-well flat-bottom dishes. A final level of 106 CFU/mL was determined through adding 280 µL of recently sown trypticase soy yeast broth (TSY) to each microplate well. The microplate was then grown in MBC at the previously determined sub-lethal concentrations of 75, 50, and 25%. Wells containing medium, only alcohol, and none of the samples were used as controls. The dishes were stored at 36 °C for 48 h. After the supernatant was disposed away, sterile distilled water was used to completely clean the drifting cells in each well. As the dishes were left to air dry for half an hour, the biofilm that had formed was colored for 15 min at ambient temperature employing a water-based mixture of 0.10% crystal violet. The excess color was removed by washing three more times with sanitized distilled water after the incubation process. A microplate reader was used to detect absorption at 570 nm following 15 min of incubating and the addition of 250 µL of 96% ethanol to the boreholes in order to finally destroy the dye affixed to the cells26,27.
Time killing test
A modified method outlined by Appiah et al.28 was used to determine the time kill kinetics of the investigated oils. After sub-culturing, H. pylori was diluted to 0.5 McFarland standard. In test tubes, sterile broth was filled with concentrations equal to, twice, and fourfold the MIC of the investigated samples. An inoculum size of 1.0 × 106 cfu/mL of the standardized organisms was subsequently inserted and the test tubes were then incubated at 37 °C. At intervals of 0, 30, 60, 120, 150, and 180 min, aliquots (1.0 mL) of the medium were extracted and thoroughly injected into media in sterilized Petri dishes. After allowing the agar to solidify, the inoculum-containing Petri dishes were incubated for 24 h at 37 °C. In addition, a control test was conducted just for the organisms. The process was carried out in triplicate, and the test organisms’ colony-forming unit (CFU) was calculated. CFU/mL was displayed against time on a table.
Anticancer testing
The MTT technique was used to determine the cytotoxic effect of unrefined and ozonized oil on PC-3 cells following their dissolution in DMSO. A cancer cell line PC-3 were placed in different wells of 96 well plate until cells adhesion to the plate for 24 h at 35 °C. Different levels (1000 −31.25µg/ml) for the examined samples were placed over the examined cancer cells(i.e.: every concertration in a seperate well). Then incubated for 24 h. The cells were stained using 100 µL of the MTT buffer (5.0 mg/mL) stain four hours at 35 °C, the outcome is a blue hue and its values are precisely related to the number of living cells. A CCD camera (3152 Olympus, Japan) attached to a microscopy to view the cells29.
Cell cycle assay
The effect of seed pumpkin oil and its ozonized form on the cell cycle stages in PC-3 cells was examined through flow cytometry. PC-3 cells were first grown for 24 h at a count of 1.7 × 106 cells/mL in a culture container made of plastic plate before being exposed to the examined samples IC50. After trypsinization, the cells were set aside at −18 °C using ice-cold 70% ethanol and rinsed with PBS buffer. The cells were then subjected to a PI buffer (Cytoflex Beckman, Germany) for half an hour at 6 °C. The cell cycle stages were examined using flow cytometry as the technique and (Cytexpert programs, Germany)30.
Antidiabetic examination
Alpha glucosidase detection
The evaluated oils were assessed for their ability to inhibit α-glucosidase using an established method that was slightly modified31. The reacted mixture was combined with the α-glucosidase (10 μL of 1 u/mL) enzyme solution and contained 50 μL of each oil at levels ranging from 1.96 to 1000 μg/mL. Following the addition of phosphate buffer (125 μL of 0.1 M at a pH of 6.7), the reaction mixture was allowed to stand for 20 min at 36 °C. 20 μL of 1 M p-nitrophenyl-α-D-glucopyranoside (pNPG) was incorporated as a substrate at the end of the time spent incubating to initiate the reaction, and it was then incubated for 30 min. To stop the reaction, 50 μL of 0.1 N Na2CO3 was subsequently added. The absorbance was measured at 410 nm.
Alpha amylase determination
To obtain ratios that vary from 1.90 to 1000.0 μg/ml, the materials were first dispersed in a minimum of 10% DMSO and then in buffer (Na2HPO4/NaH2PO4 (0.03 M), NaCl (0.007 M) at pH 6.8). 200.0 μl of the samples was combined with 200.0 μl of α-amylase liquid (2.0 units/ml) and kept for 12.0 min at 32 °C. After that, each tube received 200 μl of the solution for starch (1.0% in water (w/v)), which was then incubated for five minutes. 200 μl of DNSA reagent was added to stop the process and was heated up for 12.0 min at 80 to 90 degrees Celsius in a water bath. After cooling to room temperature, the mixture was mixed with 5.0 ml of distilled water, and the absorption value was determined at 560 nm. The specimen was substituted with 200 µl of buffer to create the Control 100.0% with 100.0% enzyme activity. With the specimen at the various concentrations, a blank reaction was made without the enzyme solution32.
Anti-obesity evaluation
Each of the examined samples was dissolved in 100 ml of DMSO to create a stock solution. Additional dilutions in the range of 25–600 µg/mL were made from it. As a substrate, p-nitrophenyl palmitate (PNPP) was employed. 2-propanol was used to make its solution (0.1132 g per 100 mL). The use of orlistat served as the positive control. The process used to generate the examined samples solution was also used to prepare its stock solutions and serial dilutions. The lipase enzyme suspension was made by mixing 1.0 mg of the enzyme with 100 mL of tris buffer (pH 7.9). After agitating the mixture for roughly ten minutes, the transparent supernatant was extracted. Lipase was boiled to create the denatured enzyme, which served as a blank. The labels“sample”and“negative control”were placed on two test tubes. The lipase solution (0.5 mL) was placed in the specimen test tube, then either specimens or the standard solution (1 mL) was added. After shaking the mixture, it was incubated for 30 min at 36 °C. One milliliter of substrate solution was incorporated after incubating. At 37 °C, the reaction mixture underwent incubation for two hours. The absorbance at 410 nm was then measured. A test tube containing 0.5 mL of lipase solution was used as the negative control. In order to maintain a consistent volume throughout all sets, 1 mL of buffer was added once more. For 30 min, the mixture was left to stand at 36 °C. One milliliter of substrate solution was then added. At 36 °C, the chemical reaction mixture was left to react for two hours. The absorbance at 410 nm was then recorded33.
Statistical examination for outcomes
The experiments have been conducted three times The results are displayed as the average ± SD for each test., the t-test (for experiments of two groups or One-way ANOVA (for experiments contained more than two variance) were used to evaluate the variance among means using Graph Pad Prism V5 (San Diego, CA, USA) software. Significant variation was defined as observations with p < 0.05.
Results
Determination of change in chemical composition upon using GC–MS assessment
GC–MS evaluation of different molecules of pumpkin seed oil and upon exposing to ozone could be seen in (Table 1 & Fig. 1). It could be noticed that unrefined and ozonized pumpkin oils contained 29 compounds where unrefined pumpkin seed oil contained a group of compounds of 11 classes which were: fatty acid esters (11); fatty acids (3), fatty acyl (1), phytosterol (3), pteridines (1), alkene (1), triterpene (2), sesquiterpenoids (2), diterpenes (2), enone (1), lignin (1), ketone (1). While, exposing of oil to ozone led to slight reduction of the content to 10 classes which consisted of 13 fatty acid esters (13), fatty acids (4), fatty acyls (2), phytosterol (1), pteridines (2), alkenes (3), Triterpene (1), Alcohol (1), lignin (1), and aldehyde (1). Besides it could be noticed that the numbers of fatty acids, pteridines, 3 alkenes and fatty acid esters had been raised upon exposure to ozone. While, only the number of phytosterols had been decreased after exposure of oil to ozone. Furthermore, a thirteen common compounds could be seen in unrefined and ozonized pumpkin oils which were: hexadecane; hexadecanoic acid, methyl ester 9-octadecenoic acid (z)-; 9,11-octadecadienoic acid, methyl ester, (E, E); Oleic acid; 9,12-Octadecadienoic acid (z, z)- 2-hydroxy-1-(hydroxy methyl) ethyl ester; 9,17-Octadecadienal, (z)-; n-Propyl 9,12-octadecadienoate; 9-octadecenoic acid (z)-, 2,3-dihydroxypropyl ester; squalene; stigmasta-3,5-diene; (+)-sesamin; and heptatriacotanol. The levels of n-Propyl 9,12-octadecadienoate was increased upon exposing oil to ozone, 9-Hexadecenoic acid, 9-hexadecenyl ester, (Z, Z)- could be seen with high level in ozonized oil only. while, three molecules were in the same levels in both forms of oil which were: hexadecane; 9-octadecenoic acid (z)- and 9,17-octadecadienal, (z)-. Finally, the rest of shared compounds have been deceased upon exposing the tested oil to ozone. A group of different derivatives could be seen in both oils.
GC–MS chromatograms revealing peaks of various bioactive compounds and them corresponding retention times in (A) unrefined pumpkin seed oil; (B) pumpkin seed oil upon exposure to ozone.
Anti-H. pylori & MIC & MBC of both forms of pumpkin seed oil
The exposure to ozone led to slight elevation of anti-H. pylori. Both forms of pumpkin seed oil had a good antibacterial role versus H. pylori with zones of inhibition for unrefined oil and exposed oil to ozone of 21.3 ± 0.6 and 23.3 ± 0.6 mm, subsequently as seen in (Fig. 2 & Table 2). Furthermore, the levels of MICs and MBCs of where: 62.5 ± 0.1, 125 ± 0.1 µg/ml for the unrefined oil were reduced to 31.25 ± 0.2, and 31.25 ± 0.2 µg/ml for the ozonized oil. Both forms of oils had a bactericidal action towards H. pylori where MBC/MIC index had been reduced upon exposure of oil to ozone (Table 3).
Agar well diffusion for antibacterial impact versus H. pylori of unrefined pumpkin seed oil (c), and exposed oil to ozone (O3) relative to both blank (B) and standard drug (SD).
Anti-biofilm roles
The anti-biofilm roles of pumpkin seed oil and exposed oil from to ozone could be seen in (Fig. 3). Both forms of oil had a notable anti-biofilm versus H. pylori at various (25, 50, and 75%) tested levels of MBC where the anti-biofilm impact of oil had been raised upon exposing of oil to ozone. Where the anti-biofilm reached its maximal level upon using 75% of MBC of ozonized pumpkin seed oil.
Anti-biofilm roles of unrefined pumpkin seed oil and upon exposure to ozone upon using 25, 50, and 75% of MBC levels (results are drawn as means ± SD).
Time killing kinetics outcome of unrefined and ozonized pumpkin oils
The antimicrobial action of unrefined and ozonized pumpkin oils over time were tested using time kill kinetics to evaluate the change in efficacy of oil forms over time. It could be noticed that there was a significant boosting (P ≤ 0.05) in the bactericidal impact of exposed oil to ozone relative to unrefined pumpkin seed oil at tested time points of 30, 60, 120, and 150 min as shown in (Table 4).
Anti-neoplastic roles of tested oils versus PC-3 cell line
Pumpkin seed oil and ozonized oil had notable anticancer roles versus PC-3 cells with IC50s = 452.69 ± 5.24, and 75.44 ± 0.69 µg/ml, respectively. Exposing of pumpkin seed oil to ozone dramatically raised (P ≤ 0.05) the antitumor role of towards PC-3 cell line as depicted in (Fig. 4 & Table 5).
Anticancer roles upon applying various levels (1000–31.25 µg/ml) of unrefined pumpkin seed oil and prior to exposure to ozone towards PC-3 cell line (prostate cancer cell line) (A) Microscopic examination using inverted microscope (Magnification = 40x); (B) Statistical analysis for viability and toxicity levels of both oil forms towards PC-3 cells (Results are represented as means ± SD).
Determination of impact of exposure of pumpkin seed oil on cell cycles
The variation of cell cycles for untreated PC-3 cells and upon exposure to unrefined and ozonized pumpkin oils was determined using flow cytometry as depicted in (Fig. 5). There is a dramatic reduction (P ≤ 0.05) in G0 in PC-3 cells upon using various oil forms relative to untreated cells. The level of check point G2/M for PC-3 cells was dramatically reduced (P ≤ 0.05) upon exposing PC-3 cells to ozonized oil while there was a non-significant change (P > 0.05) in the level of G2/M for PC-3 cells upon exposure to unrefined oil as shown in (Table 6).
Flow cytometry examination of various cell cycles in (A) Untreated PC-3 cells, (B) PC-3 cells treated by unrefined pumpkin seed oil, (C) PC-3 cells treated by ozonized pumpkin seed oil.
Detection α-glucosidase inhibition of unrefined and ozonized pumpkin oils
Both forms of oil had a notable α-glucosidase inhibition as seen in (Fig. 6). It could be noticed that the exposed oil to ozone led to significant enhancement (P ≤ 0.05) of level of α-glucosidase inhibition with IC50 = 20.47 ± 0.4 µg/ml. While, the level of inhibition for unrefined oil was 39.36 ± 0.6 µg/ml.
Detection of α-glucosidase inhibition using various oil forms relative to acrobase (results are drawn as means ± SD; various letters above columns refer to dramatic difference where P ≤ 0.05; IC50 (O3 oil) = 20.47 ± 0.4 µg/ml, (unrefined oil) = 39.36 ± 0.6 µg/ml and IC 50(acrobase standard) = 7.06 ± 0.4 µg/ml.
Evaluation α-amylase inhibition of unrefined and ozonized pumpkin oils
It could be detected that unrefined pumpkin seed oil has a level of α-amylase inhibition at IC50 = 47.5 ± 0.3 µg/ml. While exposure of oil to ozone led to slight improvement of α-amylase inhibition impact with IC50 = 35.19 ± 0.2 µg/ml. i.e.: Exposure to ozone had a minimal impact of α-amylase inhibition of oil as seen in (Fig. 7).
Detection of α-amylase inhibition for various oil forms compared to acrobase (outcomes are drawn as means ± SD; different letters above columns refer to dramatic difference where P ≤ 0.05; IC50 (O3 oil) = 35.19 ± 0.2 µg/ml, (unrefined oil) = 47.5 ± 0.3 µg/ml and IC 50(acrobase standard) = 5.56 ± 0.3 µg/ml.
Assessment of lipase inhibition by examined oil forms
It could be detected that unrefined pumpkin seed oil has a weak lipase inhibition level with IC50 = 30.32 ± 0.6 µg/ml. While, exposure of oil to ozone led to dramatic improvement (P ≤ 0.05) of lipase inhibition level with IC50 = 9.21 ± 0.8 µg/ml (Fig. 8).
Detection of α-amylase inhibition for various oil forms compared to orlistat (outcomes are drawn as means ± SD; different letters above columns refer to dramatic difference where P ≤ 0.05; IC50 (O3 oil) = 9.21 ± 0.8 µg/ml, (unrefined oil) = 30.32 ± 0.6 µg/ml and IC 50(orlistat standard) = 5.89 ± 0.8 µg/ml.
Discussion
The food manufacturing sector seeks new natural substances to utilize as biological agents that are not synthetic in healthcare settings in order to meet the needs of consumers for chemical-free and healthful products34. The process of bio-transformation using biological agents generated from plants is crucial for ensuring food safety and security while simultaneously giving food products new useful features35.
There is a restricted planting of pumpkins planned for seed production and their uses in food products such as desserts or used in raw or grilled form36. Additionally, seeds can be used for oil extraction, which exhibits multiple positive health advantages due to their content in beneficial substances such as fatty acids, tocopherols, and phytosterols37. Pumpkin seeds have become popular for their impact on health, and rising consumption trends have been observed in recent years6. Because seeds are typically discarded during the preparation of fruit, locating new potential applications could boost the additional value of the pumpkin crop in the scheme of the circular economy38. Furthermore, studies have demonstrated how various biotechnology-related techniques can be used to improve the biological and endurance properties of natural oils in order to increase their therapeutic value19,39.
In the present work, pumpkin seed oil was exposed to ozone at a rate of rate of 0 to 8 L/minute for 6 h. Ozonized oils are produced using ozone generators, and a variety of variables can affect how effective ozonized products are. Some of the elements that influence ozonation procedures include the type and quantity of vegetal oil; the inclusion of water or a different catalyst; both the effectiveness and the caliber of ozone makers; and ozonation conditions, such as time frame, ozone and power level, temperatures, and reaction product motion40,41. Checking physiological properties42 is one approach to assess the quality of the ozonized oils that are produced; these criteria are essential for identification and analysis.
The total number of compounds has not been changed upon exposure of pumpkin seed oil to ozone. However, the number of classes as well as the type of molecules as well as their levels has been altered upon exposing the tested oil to ozone. Researchers investigated the decomposition of fatty acid ozonides through GC/MS analyses of the volatile component of oil when subjected to ozone; they found that the resulting compounds include carboxylic acids, fatty acid esters, and furyl derivatives. It is crucial to remember that light and/or humidity can affect glyceryl oil-based ozonides, which can promote several degradation methods, the primary one of which is the production of aldehydes43,44.
In this investigation, exposing pumpkin seed oil to ozone resulted in a slight increase in anti-H. pylori impact which has been confirmed by kinetics assay which confirm the treated pumpkin oil has a better anti-H. pylori in earlier time. Numerous studies have demonstrated the potential use of unrefined pumpkin seed oil as an adjuvant treatment in animals contaminated with antimicrobial properties4,45. It has been demonstrated that adding ozone may enhance the characteristics of oils and its antimicrobial effects. Ozone’s greater oxidizing qualities cause microbes’ exterior walls to decay down, making them easier to penetrate and allowing ozone to penetrate18. 9-Hexadecenoic acid, 9-hexadecenyl ester, (Z, Z)- and n-Propyl 9,12-octadecadienoate consider as unsaturated and saturated fatty acids with effective antimicrobial activity towards Gram negative bacteria1.
The toxic effect of the investigated oil types to PC-3 cells was evaluated in order to investigate their possible anticancer function. The ozonized oil’s cytotoxic qualities seemed encouraging. Their protective and anticancer activities, on the other hand, were revealed by numerous investigators46. Additionally, Abou Seif47 showed that pumpkin oil can shield the liver from oxidative damage and induced hepatotoxicity in experimental animals. This might be due to the high levels of 9-Hexadecenoic acid, 9-hexadecenyl ester, (Z,Z)- and n-Propyl 9,12-octadecadienoate in the ozonized oil. The anticancer impact of ozonized oil had been confirmed by induction of early apoptosis which had been showed by cell cycle assay. In accordance with Budi et al.48 who reported the apoptotic impact of hexadecanoic acid towards oral squamous cell carcinoma. Moreover, Wang et al.49 showed the role of palmitic acid for induction of apoptosis through mitochondrial cascade. Additionally, many recent reports highlighted the effective anticancer role for octadecadienic acid in natural products50,51.
Pumpkin seeds contain active-hypoglycemic compounds, and detailed the anti-diabetic properties of various pumpkin parts and oil52. In the present work exposure of pumpkin seed oil to ozone promote antidiabetic properties of the oil through enhance the level of inhibitions to alpha-amylase and alpha glucosidase enzymes. Both 9-Hexadecenoic acid, 9-hexadecenyl ester, (Z,Z)-, and n-Propyl 9,12-octadecadienoate were reported as predominant molecules in ozonized oil which reported to have antidiabetic activity as reported by Nahar et al.53,.
Pumpkin seed oil is a natural supplier of antioxidant molecules and phytosterols and is advised for incorporation into human diets for health because it lowers hypercholesterolemia54. A great source of vital minerals, pumpkin seeds have health benefits as it contained a high content bioactive molecule55. Many biochemical functions markedly optimized by oils obtained from raw pumpkin seeds56,. Extracted pumpkin peel and seed combinations showed substantial levels of oleic, and linolenic acids57. The present resulted revealed that the exposure of oil to ozone enhances anti-obesity impact through inhibition of lipase enzyme inhibition.
Conclusion
The present results suggest that ozone placed on pumpkin oil at a flow rate of 0 to 8 L/minute for 6 h changes the corresponding amounts of biologically active compounds, especially by increasing the level n-Propyl 9,12-octadecadienoate in the ozonized oil as well as the existence of of 9-Hexadecenoic acid, 9-hexadecenyl ester, (Z,Z)- in ozonized oil. This could explain the differences in the molecules’ in vitro anti-H. pylori, anticancer on PC-3 cells, and anti-diabetic and obesity-fighting abilities. In general, there is still room for more clinical studies and live experimental models in the scientific analysis of ozonized pumpkin seed oil for usage of this approach.
Data availability
The results from the current investigation are available from the corresponding author (Tarek M. Abdelghany: tabdelghany.201@azhar.edu.eg) upon reasonable appeal.
References
Leichtweis, M. G. et al. Biological activity of pumpkin byproducts: Antimicrobial and antioxidant properties. Molecules 27(23), 8366. https://doi.org/10.3390/molecules27238366 (2022).
Selim, S. et al. Estimation and action mechanisms of cinnamon bark via oxidative enzymes and ultrastructures as antimicrobial, anti-biofilm, antioxidant, anti-diabetic, and anticancer agents. BioResources 19(4), 7019–7041. https://doi.org/10.15376/biores.19.4.7019-7041 (2024).
Besrour, N. et al. Valorization of Juglans regia leaves as cosmeceutical ingredients: Bioactivity evaluation and final formulation development. Antioxidants (Basel). 11(4), 677. https://doi.org/10.3390/antiox11040677 (2022).
Amin, M. Z., Rity, T. I., Uddin, M. R., Rahman, M. M. & Uddin, M. J. A comparative assessment of anti-inflammatory, anti-oxidant and anti-bacterial activities of hybrid and indigenous varieties of pumpkin (Cucurbita maxima Linn.) seed oil. Biocatalysis. Agric. Biotechnol. 28, 101767 (2020).
Alasalvar, C., Chang, S. K., Bolling, B., Oh, W. Y. & Shahidi, F. Specialty seeds: Nutrients, bioactives, bioavailability, and health benefits: A comprehensive review. Compr. Rev. Food Sci. Food Saf. 20(3), 2382–2427 (2021).
Rabrenovic, B. B., Dimic, E. B., Novakovic, M. M., Tesevic, V. V. & Basic, Z. N. The most important bioactive components of cold pressed oil from different pumpkin (Cucurbita pepo L.) seeds. LWT Food Sci. Technol. 55, 521–527. https://doi.org/10.1016/j.lwt.2013.10.019 (2014).
da Cruz, G. K. et al. Evaluation of the efficacy and toxicity of oral and topical pumpkin oil on the hair growth of mice. Acta Histochem. 124(4), 151894 (2022).
Boaduo, N. K., Katerere, D., Eloff, J. N. & Naidoo, V. Evaluation of six plant species used traditionally in the treatment and control of diabetes mellitus in South Africa using in vitro methods. Pharm. Biol. 52, 756–761. https://doi.org/10.3109/13880209.2013.869828 (2014).
Bardaa, S. et al. Oil from pumpkin (Cucurbita pepo L.) seeds: Evaluation of its functional properties on wound healing in rats. Lipid. Health Dis. https://doi.org/10.1186/s12944-016-0237-0 (2016).
Adsul S, Madkaikar V Pumpkin (Cucurbita pepo) seed In Oilseeds: Health Attributes and Food Applications 473–506 https://doi.org/10.1007/978-981-15-4194-0_19 (Springer, Singapore, 2021).
Nawirska-Olszańska, A., Kita, A., Biesiada, A., Sokół-Łętowska, A. & Kucharska, A. Z. Characteristics of antioxidant activity and composition of pumpkin seed oils in 12 cultivars. Food Chem. 139, 155–161. https://doi.org/10.1016/j.foodchem.2013.02.009 (2013).
Jian, L., Du, C. J., Lee, A. H. & Binns, C. W. Do dietary lycopene and other carotenoids protect against prostate cancer?. Int. J. Cancer. 113, 1010–1014. https://doi.org/10.1002/ijc.20667 (2005).
Alhakamy, N. A., Fahmy, U. A. & Ahmed, O. A. A. Attenuation of benign prostatic hyperplasia by optimized tadalafil loaded pumpkin seed oil-based self nanoemulsion: In vitro and in vivo evaluation. Pharmaceutics 11(12), 640 (2019).
Adnan, M. et al. A review on the ethnobotany, phytochemistry, pharmacology and nutritional composition of Cucurbita pepo L. J. Phytopharmacol. 6(2), 133–139 (2017).
Smith, N. L., Wilson, A. L., Gandhi, J., Vatsia, S. & Khan, S. A. Ozone therapy: An overview of pharmacodynamics, current research, and clinical utility. Med. Gas. Res. 7, 212–219. https://doi.org/10.4103/2045-9912.215752 (2017).
Zeng, J. & Lu, J. Mechanisms of action involved in ozone-therapy in skin diseases. Int. Immunopharmacol. 56, 235–241. https://doi.org/10.1016/j.intimp.2018.01.040 (2018).
Al-Rajhi, A. M. et al. Effect of ozonation on the phytochemicals of black seed oil and its anti-microbial, anti-oxidant, anti-inflammatory, and anti-neoplastic activities in vitro. Sci. Rep. 14, 30445. https://doi.org/10.1038/s41598-024-81157-9 (2024).
Wadhwa, G., Kumar, S., Mittal, V. & Rao, R. Encapsulation of babchi essential oil into microsponges: Physicochemical properties, cytotoxic evaluation and anti-microbial activity. J. Food Drug. Anal. 27, 60–70. https://doi.org/10.1016/j.jfda.2018.07.006 (2019).
Borges, G. Á. et al. In vitro evaluation of wound healing and antimicrobial potential of ozone therapy. J. Cranio-Maxillofac. Surg. 45, 364–370. https://doi.org/10.1016/j.jcms.2017.01.005 (2017).
Ugazio, E., Tullio, V., Binello, A., Tagliapietra, S. & Dosio, F. Ozonated oils as antimicrobial systems in topical applications. Their characterization current applications, and advances in improved delivery techniques. Molecules 25(2), 334. https://doi.org/10.3390/molecules25020334 (2020).
Al-Rajhi, A. M. H. et al. Phytochemical characterization of peanut oil and its ozonized form to explore biological activities in vitro. AMB Express 15(1), 76. https://doi.org/10.1186/s13568-025-01849-x (2025).
Abdelghany, T. M., Hassan, M. M. & El-Naggar, M. A. GC/MS analysis of Juniperus procera extract and its activity with silver nanoparticles against Aspergillus flavus growth and aflatoxins production. Biotechnol. Rep. (Amst). 27, 00496 (2020).
Yahya, R. et al. Molecular docking and efficacy of aloe vera gel based on chitosan nanoparticles against Helicobacter pylori and its antioxidant and anti-inflammatory activities. Polymer 14, 2994. https://doi.org/10.3390/polym14152994 (2022).
Shakir, S. M. et al. multicenter evaluation of a gradient diffusion method for antimicrobial susceptibility testing of Helicobacter pylori. Microbiol. Spectr. 10(2), e0211121. https://doi.org/10.1128/spectrum.02111-21 (2022).
Huang, X. et al. Minimum inhibitory concentrations of commonly used antibiotics against Helicobacter pylori: A multicenter study in South China. PLoS ONE 16(9), e0256225. https://doi.org/10.1371/journal.pone.0256225 (2021).
Al-Rajhi, A. M. H. et al. Anti-Helicobacter pylori, antioxidant, antidiabetic, and anti-alzheimer’s activities of laurel leaf extract treated by moist heat and molecular docking of its flavonoid constituent, naringenin, against Acetylcholinesterase and Butyrylcholinesterase. Life (Basel). 13(7), 1512. https://doi.org/10.3390/life13071512 (2023).
Al-Rajhi, A. M. H. & Abdelghany, T. M. In vitro repress of breast cancer by bio-product of edible Pleurotus ostreatus loaded with chitosan nanoparticles. Appl. Biol. Chem. 66, 33. https://doi.org/10.1186/s13765-023-00788-0 (2023).
Qanash, H. et al. Inhibitory potential of rutin and rutin nano-crystals against Helicobacter pylori, colon cancer, hemolysis and Butyrylcholinesterase in vitro and in silico. Appl. Biol. Chem. 66, 79. https://doi.org/10.1186/s13765-023-00832-z (2023).
Appiah, T., Boakye, Y. D. & Agyare, C. Antimicrobial activities and time-kill kinetics of extracts of selected Ghanaian mushrooms. Evid.-Based. Complement. Altern. Med. 2017, 15. https://doi.org/10.1155/2017/4534350.4534350 (2017).
Hasanin, M., Al Abboud, M. A., Alawlaqi, M. M., Abdelghany, T. M. & Hashem, A. H. Ecofriendly synthesis of biosynthesized copper nanoparticles with starch-based nanocomposite: Antimicrobial, antioxidant, and anticancer activities. Biol. Trace. Elem. Res. 200(5), 2099–2112. https://doi.org/10.1007/s12011-021-02812-0 (2022).
Esnaashari, F. et al. Berberine decorated zinc oxide loaded chitosan nanoparticles a potent anti-cancer agent against breast cancer. Sci. Rep. 15(1), 3185. https://doi.org/10.1038/s41598-025-87445-2 (2025).
Tsai, C. H., Liou, Y. L., Li, S. M., Liao, H. R. & Chen, J. J. Antioxidant, Anti-α-glucosidase, anti-tyrosinase, and anti-acetylcholinesterase components from stem of Rhamnus formosana with molecular docking study. Antioxidant. (Basel). 14(1), 8. https://doi.org/10.3390/antiox14010008 (2024).
Wickramaratne, M. N., Punchihewa, J. C. & Wickramaratne, D. B. M. In-vitro alpha amylase inhibitory activity of the leaf extracts of Adenanthera pavonina. BMC Complement. Altern. Med. 16, 466. https://doi.org/10.1186/s12906-016-1452-y (2016).
Noor, Z. I. et al. In Vitro antidiabetic, anti-obesity and antioxidant analysis of Ocimum basilicum aerial biomass and in silico molecular docking simulations with alpha-amylase and lipase enzymes. Biology 8(4), 92. https://doi.org/10.3390/biology8040092 (2019).
Petropoulos, S. A. et al. Antimicrobial properties, cytotoxic effects, and fatty acids composition of vegetable oils from purslane, linseed, luffa, and pumpkin seeds. Appl. Sci. 11(12), 5738. https://doi.org/10.3390/app11125738 (2021).
Qanash, H. et al. Effectiveness of oil-based nanoemulsions with molecular docking of its antimicrobial potential. BioResources 18, 1554–1576 (2023).
Seymen, M., Uslu, N., Türkmen, Ö., Al Juhaimi, F. & Özcan, M. M. Chemical compositions and mineral contents of some hull-less pumpkin seed and oils. JAOCS J. Am. Oil Chem. Soc. 93, 1095–1099 (2016).
Vujasinovic, V., Djilas, S., Dimic, E., Romanic, R. & Takaci, A. Shelf life of cold-pressed pumpkin (Cucurbita pepo L.) seed oil obtained with a screw press. JAOCS J. Am. Oil Chem. Soc. 87, 1497–1505 (2010).
Can-Cauich, C. A., Sauri-Duch, E., Moo-Huchin, V. M., Betancur-Ancona, D. & Cuevas-Glory, L. F. Effect of extraction method and specie on the content of bioactive compounds and antioxidant activity of pumpkin oil from Yucatan. Mexico. Food Chem. 285, 186–193 (2019).
Guerra, B. P., Poznyak, T., Chairez, I. & Brito, A. M. Correlation of structural characterization and viscosity measurements with total unsaturation: An effective method for controlling ozonation in the preparation of ozonated grape seed and sunflower oils. Eur. J. Lipid Sci. Technol. 117, 988–998. https://doi.org/10.1002/ejlt.201400292 (2015).
Cirlini, M., Caligiani, A., Palla, G., de Ascentiis, A. & Tortini, P. Stability studies of ozonized sunflower oil and enriched cosmetics with a dedicated peroxide value determination. Ozone: Sci. Eng. 34, 293–299 (2012).
Boland-Nazar, N. S., Eslamirad, Z., Sarmadian, H. & Ghasemikhah, R. An in vitro evaluation of ozonized organic extra-virgin olive oil on Giardia lamblia cysts. Jundishapur J. Microbiol. 9, 11 (2016).
Sadowska, J. et al. Characterization of ozonated vegetable oils by spectroscopic and chromatographic methods. Chem. Phys. Lipids. 151, 85–91. https://doi.org/10.1016/j.chemphyslip.2007.10.004 (2008).
Sega, A. et al. Properties of sesame oil by detailed 1H and 13C NMR assignments before and after ozonation and their correlation with iodine value, peroxide value, and viscosity measurements. Chem. Phys. Lipids. 163(2), 148–156. https://doi.org/10.1016/j.chemphyslip.2009.10.010 (2010).
Ozturk, B. et al. The effects of ozone on bacterial growth and thiol-disulphide homeostasis in vascular graft infection caused by MRSA in rats. Acta Cir. Bras. 32, 219–228 (2017).
Soares, K. et al. Evaluation of hygienic quality of food served in universities canteens of northem portugal. Ind. J. Microbiol. 60, 107–114. https://doi.org/10.1007/s12088-019-00844-8 (2020).
Dotto, J. M. & Chacha, J. S. The potential of pumpkin seeds as a functional food ingredient: A review. Sci. Afr. 10, e00575. https://doi.org/10.1016/j.sciaf.2020.e00575 (2020).
Abou Seif, H. S. Ameliorative effect of pumpkin oil (Cucurbita pepo L.) against alcohol-induced hepatotoxicity and oxidative stress in albino rats. Beni-Suef Univ. J. Basic Appl. Sci. 3, 178–185. https://doi.org/10.1016/j.bjbas.2014.08.001 (2014).
Budi, H. S. et al. Palmitic acid of Musa Paradisiaca induces apoptosis through caspase-3 in human oral squamous cell carcinoma. Eur. Rev. Med. Pharmacol. Sci. 26(19), 7099–7114. https://doi.org/10.26355/eurrev_202210_29895 (2022).
Wang, X., Zhang, C. & Bao, N. Molecular mechanism of palmitic acid and its derivatives in tumor progression. Front. Oncol. 13, 1224125. https://doi.org/10.3389/fonc.2023.1224125 (2023).
Gharby, S. & Charrouf, Z. Argan oil: Chemical composition, extraction process, and quality control. Front. Nutr. 8, 804587. https://doi.org/10.3389/fnut.2021.804587 (2022).
Almuhayawi, M. S. et al. In vitro and in silico biopotentials of phytochemical compositions and antistaphylococcal and antipseudomonal activities of volatile compounds of Argania spinose (L.) seed oil. Bioeng. Biotechnol. 12, 1348344. https://doi.org/10.3389/fbioe.2024.1348344 (2024).
Adams, G. G. et al. The hypoglycaemic effect of pumpkins as anti-diabetic and functional medicines. Food Res. Int. https://doi.org/10.1016/j.foodres.2011.03.016 (2011).
Nahar, N. et al. Profiling of secondary metabolite and evaluation of anti-diabetic potency of Crotalaria quinquefolia (L): In-vitro, in-vivo, and in-silico approaches. Saudi Pharm. J. 32(1), 101887. https://doi.org/10.1016/j.jsps.2023.101887 (2024).
Ayyıldız, HF., Topkafa, M., Kara, H. Pumpkin (Cucurbita pepo L.) seed oil, fruit oils: chemistry and functionality https://doi.org/10.1007/978-3-030-12473-1_41 (2019).
Nameni, RO., Woumbo, CY., Kengne, AP., Zokou, R., Tekou, FA., Nguekouo, PT., Kuate D. Effects of stifled cooking on the quality and lipid-lowering potential of oils extracted from two species of pumpkin seeds (Citrullus lanatus and Cucumeropsis mannii). Pharmacology. 4(1) (2021).
Cuco, R. P., Cardozo-Filho, L. & da Silva, C. Simultaneous extraction of seed oil and active compounds from peel of pumpkin (Cucurbita maxima) using pressurized carbon dioxide as solvent. J. Supercrit. Fluid. 143, 8–15. https://doi.org/10.1016/j.supflu.2018.08.002 (2019).
Funding
This work was supported and funded by the Deanship of Scientific Research at Imam Mohammad Ibn Saud Islamic University (IMSIU) (grant number IMSIU-DDRSP2501).
Author information
Authors and Affiliations
Contributions
S.A.A., and M.I.A. Investigation, writing—review and editing; A.M.M., A.F.K., F. S. A. Conceptualization and methodology, T.M.A. Formal analysis, writing—review and editing. All authors agreed to the published version of the manuscript.
Corresponding author
Ethics declarations
Competing interests
The authors declare no competing interests.
Additional information
Publisher’s note
Springer Nature remains neutral with regard to jurisdictional claims in published maps and institutional affiliations.
Rights and permissions
Open Access This article is licensed under a Creative Commons Attribution-NonCommercial-NoDerivatives 4.0 International License, which permits any non-commercial use, sharing, distribution and reproduction in any medium or format, as long as you give appropriate credit to the original author(s) and the source, provide a link to the Creative Commons licence, and indicate if you modified the licensed material. You do not have permission under this licence to share adapted material derived from this article or parts of it. The images or other third party material in this article are included in the article’s Creative Commons licence, unless indicated otherwise in a credit line to the material. If material is not included in the article’s Creative Commons licence and your intended use is not permitted by statutory regulation or exceeds the permitted use, you will need to obtain permission directly from the copyright holder. To view a copy of this licence, visit http://creativecommons.org/licenses/by-nc-nd/4.0/.
About this article
Cite this article
Alsalamah, S.A., Alghonaim, M.I., Mohammad, A.M. et al. Ozone-modified properties of pumpkin seed oil as anti-H. pylori, anticancer, anti-diabetic and anti-obesity agent. Sci Rep 15, 25959 (2025). https://doi.org/10.1038/s41598-025-11123-6
Received:
Accepted:
Published:
Version of record:
DOI: https://doi.org/10.1038/s41598-025-11123-6
Keywords
This article is cited by
-
Anticancer potential of nanoemulsion-treated white mulberry and its leaves on MCF-7 cells
Scientific Reports (2025)